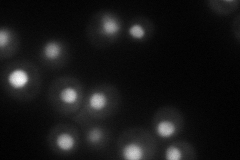
YLL034C
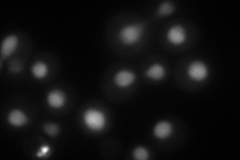
YLL034C
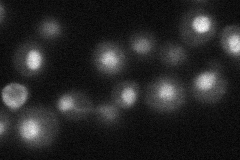
YLL034C
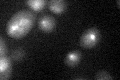
YLL034C

View description
Putative ATPase of the AAA family, required for export of pre-ribosomal large subunits from the nucleus; distributed between the nucleolus, nucleoplasm, and nuclear periphery depending on growth conditions
Localization:
Intensity:
Fold change:
Significance:
-
C’ GFP library in SD

nucleus36.92 -
N' NOP1pr-GFP in SD
nucleus117.562 -
N' TEF2pr-mCherry in SD
nucleus132.924 -
N' NATIVEpr-GFP in SD
nucleus28.597 -
N' TEF2pr-VC and Cyto-VN in SD

#N/A0 -
C’ GFP library in SD+DTT

nucleus26.490.71No -
C’ GFP library in SD+H2O2

nucleus41.741.13No -
C’ GFP library in Starvation Media

nucleus21.660.58Yes -
C’ GFP library on the background of Pup2-DaMP
punctate -
C’ GFP library on the background of CCT mutant

nucleus38.55231.04406No
